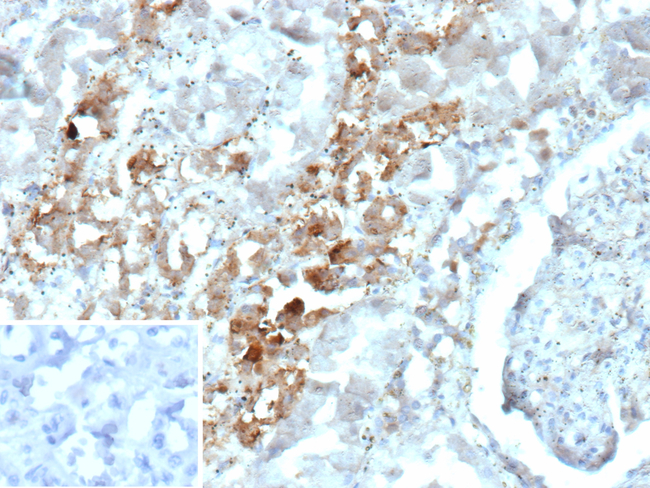
Parvalbumin/PVALB Antibody in Immunohistochemistry (Paraffin) (IHC (P))

Search
NeoBiotechnologies
Parvalbumin/PVALB Recombinant Rabbit Monoclonal Antibody (PVALB/12610R)
{{$productOrderCtrl.translations['antibody.pdp.commerceCard.promotion.promotions']}}
{{$productOrderCtrl.translations['antibody.pdp.commerceCard.promotion.viewpromo']}}
{{$productOrderCtrl.translations['antibody.pdp.commerceCard.promotion.promocode']}}: {{promo.promoCode}} {{promo.promoTitle}} {{promo.promoDescription}}. {{$productOrderCtrl.translations['antibody.pdp.commerceCard.promotion.learnmore']}}
产品信息
5816-RBM4-P1ABX
种属反应
宿主/亚型
Expression System
分类
类型
克隆号
抗原
偶联物
形式
浓度
规格
纯化类型
保存液
内含物
保存条件
运输条件
产品详细信息
Product cellular localization: Cell junction, Nucleus.
Positive control: Human brain, heart or kidney.
靶标信息
Parvalbumin (PV) is a calcium binding protein expressed in specific muscle fibers and fast-firing neurons. PV consists of a single, unbranched chain of linked amino acids and belongs to a larger group of EF hand proteins. Studies have demonstrated that parvalbumin acts in the decay of calcium in the contraction/ relaxation cycle of fast twitch muscles. This data has shown a positive correlation between the rate of relaxation and the concentration of parvalbumin. Parvalbumin is also expressed in a specific population of GABAergic interneurones which are thought to play a role in maintaining the balance between excitation and inhibition in the cortex as well as the hippocampus. In amyotrophic lateral sclerosis (ALS) patents, parvalbumin immunoreactivity is specifically absent from neuron populations lost early in ALS.
仅用于科研。不用于诊断过程。未经明确授权不得转售。
篇参考文献 (0)
生物信息学
蛋白别名: Alpha-parvalbumin; Alpha-PV; HGNC:9704; MGC116759; parvalbumin; Parvalbumin alpha; PVALB; unnamed protein product
基因别名: D22S749; PVALB
UniProt ID: (Human) P20472
Entrez Gene ID: (Human) 5816